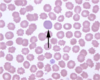
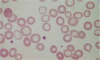
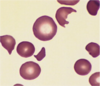
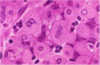
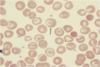

Pictures Flashcards
(25 cards)
What is shown in this picture?
arrow pointing at an example of polychromasia
note the grey blue cell without central pallor
this implies the presence of reticulocytes
some people say you need to correct the reticulocyte count for polychromasia by dividing it by 2.
What is shown in this pic?

extramedullary hematopoiesis as a response to anemia
bone marrow expansion
Here…which cells demonstrate a low MCHC & which demonstrate a high MCHC?
the ones that look less pink–>low MCHC–>defective synthesis of hemoglobin
the ones that are super pink & spherical–>high MCHC–>hereditary spherocytosis
What can you see in this pic?

see bone marrow!
Note the megakaryocyte
see some trabecular bone
brown stuff–iron in the bone marrow
Do you know what this diagram represents?

Awesome!
What does this pic show?

esophageal web
fibrous band that constricts!
makes it hard to swallow
a possible part of plummer vinson syndrome
could indicate iron deficiency anemia
What does this pic show?

glossitis
with angular stomatitis
could be a part of plummer vinson syndrome
could indicate iron deficiency anemia or B6 deficiency
What does this pic show?

koilonychia
the nail spoons upward
could be a part of plummer vinson
could indicate iron deficiency anemia
What is the rate limiting step in this process?

delta ALA–>porphobilinogen.
What is shown in this pic?

blue gum line–burton’s line
indicative of sideroblastic anemia
What is shown in this pic?

ringed sinderoblasts in the bone marrow
indicative of sideroblastic anemia
This pic shows the structure of which cell type? Which of these would potentially be mutated in hereditary spherocytosis? In hereditary elliptocytosis?

RBC
Hereditary Spherocytosis: Ankyrin (most common) also: band 3, spectrins, protein 4.2
Hereditary Elliptocytosis: spectrin or protein 4.1
Which abnormality is displayed here?

hereditary spherocytosis
Which abnormality does this pic show?

hereditary elliptocytosis
Which abnormality does this pic show? What are some of the stressors that can cause this?

sickle cell anemia
Stressors:
- low ph
- low oxygen tension
- Volume depletion
What caused the damage shown in this pic?

renal papillary necrosis secondary to sickle cell anemia
pt will likely show microhematuria
What is shown in this pic?

g6pd deficiency–Mediterranean form
Main pic: bite cells–>macrophage removal of damaged membrane
Little pic: Heinz bodies–>precipitate of oxidized hemoglobin
Just something to think about…

: )
Which abnormality is shown in this pic? What are its possible causes?
Traumatic Hemolysis
Note the schistocytes, burr cells, helmet cells
Possible Causes: DIC, long distance running, prosthetic heart valves, TTP
What condition might these cells be associated with?

Burr cells
associated perhaps with renal disease (uremia)
can sometimes get normocytic anemia with this
these are shrunken RBCs with irregular projections (echinocytes)
Which abnormality does this pic show? What are 2 possible causes of this?

megaloblastic anemia
could be folate or vb12 deficiency
falls into the category of macrocytic anemia
**note that mitosis is messed up–that’s why the huge nucleus & the cytoplasm is getting pinker b/c they are producing hemoglobin!
Which abnormality is shown here?
prob pernicious anemia
these are parietal cells that are being attacked by autoantibodies
will lead to vb12 deficiency & a megaloblastic macrocytic anemia
What are the possible causes for the image shown here?

this is a hypersegmented neutrophil, as in more than 5 lobes; formed b/c of impaired division of granulocytic precursors
signals that you have a megaloblastic macrocytic anemia going on
either folate or VB12 deficiency
Just another fun chart…

yay!